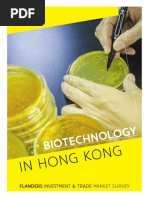

0% found this document useful (0 votes)
2K views61 pagesEC Legend Final Coaching
The document discusses various medical laboratory tests and procedures. It provides information on topics like hematology, clinical chemistry, microbiology, quality control, and specimen collection and processing. Key points include different types of blood cells and cell counts, quality control procedures using internal and external standards, separating plasma from whole blood through centrifugation, and ensuring sample purity for accurate test results.
Uploaded by
Virna Grace MonteroCopyright
© © All Rights Reserved
We take content rights seriously. If you suspect this is your content, claim it here.
Available Formats
Download as PDF, TXT or read online on Scribd
0% found this document useful (0 votes)
2K views61 pagesEC Legend Final Coaching
The document discusses various medical laboratory tests and procedures. It provides information on topics like hematology, clinical chemistry, microbiology, quality control, and specimen collection and processing. Key points include different types of blood cells and cell counts, quality control procedures using internal and external standards, separating plasma from whole blood through centrifugation, and ensuring sample purity for accurate test results.
Uploaded by
Virna Grace MonteroCopyright
© © All Rights Reserved
We take content rights seriously. If you suspect this is your content, claim it here.
Available Formats
Download as PDF, TXT or read online on Scribd